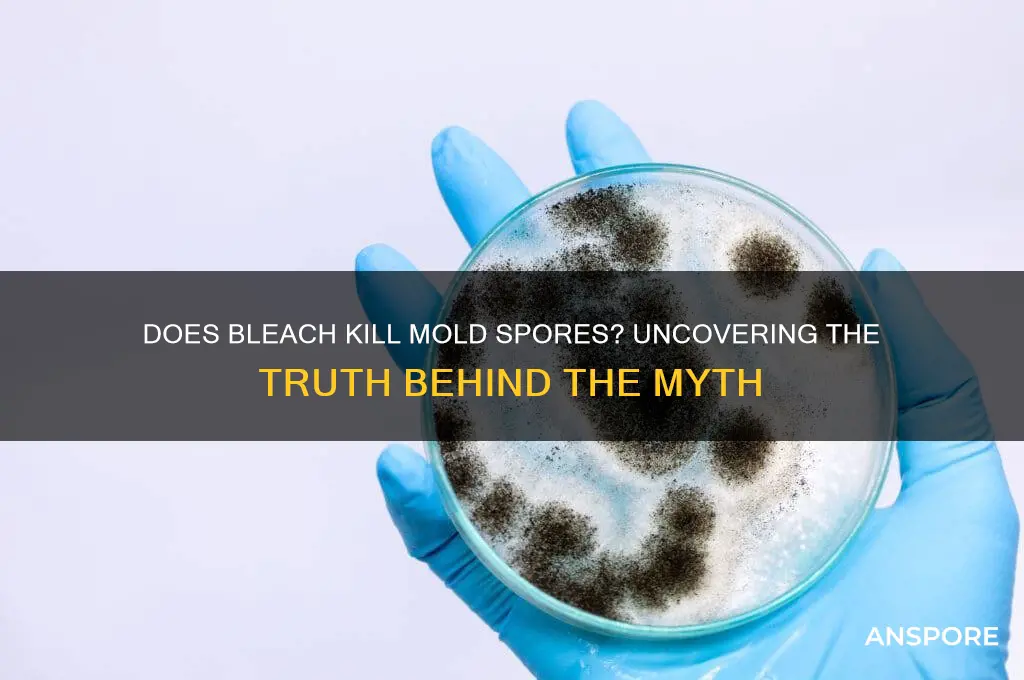
does bleach kill mold spores

Bleach is a common household cleaner often used to tackle mold, but its effectiveness in killing mold spores is a topic of debate. While bleach can remove visible mold stains and disinfect surfaces, it primarily works on non-porous materials and may not penetrate porous surfaces where mold roots can thrive. Additionally, bleach contains water, which can actually feed mold growth if not used correctly. Mold spores are resilient and require specialized treatments to be fully eradicated, leaving many to question whether bleach is a reliable solution or if alternative methods, such as vinegar or professional mold removers, are more effective in addressing the issue at its source.
| Characteristics | Values |
|---|---|
| Effectiveness on Mold Spores | Bleach can kill surface mold but is less effective on porous surfaces. |
| Active Ingredient | Sodium hypochlorite (typically 5-8% concentration in household bleach). |
| Surface Suitability | Best for non-porous surfaces like glass, tiles, and countertops. |
| Porous Materials | Ineffective on wood, drywall, or fabrics as it doesn't penetrate deeply. |
| Mold Spores Survival | Mold spores can survive bleach treatment on porous surfaces. |
| Discoloration Risk | May discolor or damage certain materials (e.g., fabrics, metals). |
| Health and Safety | Toxic fumes; requires proper ventilation and protective gear. |
| Environmental Impact | Harmful to the environment if not disposed of properly. |
| Alternative Solutions | Vinegar, hydrogen peroxide, or commercial mold removers are often preferred for porous surfaces. |
| Prevention | Does not prevent mold regrowth; addresses only visible mold. |
Explore related products
What You'll Learn

Effectiveness of bleach on mold spores
Bleach, a common household disinfectant, is often the first remedy people turn to when tackling mold. However, its effectiveness against mold spores is a subject of debate. While bleach can kill mold on non-porous surfaces like glass or tile, it falls short when applied to porous materials such as drywall or wood. Mold spores penetrate deeply into these materials, and bleach’s inability to permeate beyond the surface means it only addresses visible mold, leaving spores intact and capable of regrowth.
To use bleach effectively, mix 1 cup of bleach per gallon of water, ensuring proper dilution to avoid surface damage. Apply the solution to non-porous surfaces using a spray bottle or cloth, allowing it to sit for 10–15 minutes before scrubbing and rinsing. Despite this, bleach’s limitations on porous surfaces highlight the need for alternative solutions, such as vinegar or specialized mold removers, which can penetrate more deeply.
From a comparative standpoint, bleach’s active ingredient, sodium hypochlorite, is effective against surface mold but lacks the ability to address the root problem. Unlike fungicides designed to inhibit mold growth, bleach does not prevent future infestations. Additionally, its harsh chemical nature poses health risks, including skin irritation and respiratory issues, especially in poorly ventilated areas. This makes it less ideal for long-term or large-scale mold remediation.
A practical takeaway is that bleach serves as a quick fix for surface mold on non-porous materials but is not a comprehensive solution. For porous surfaces or extensive mold growth, consider professional remediation or products specifically formulated to kill mold spores. Always wear protective gear, such as gloves and a mask, when handling bleach, and ensure the area is well-ventilated to minimize health risks. Understanding bleach’s limitations ensures more effective and safer mold management.
How Long Do Mold Spores Stay Airborne and Pose Risks?
You may want to see also

Bleach vs. mold on porous surfaces
Bleach, a common household disinfectant, is often the first remedy people turn to when tackling mold. However, its effectiveness against mold spores on porous surfaces like wood, drywall, or grout is a subject of debate. While bleach can kill surface mold, its inability to penetrate deeply into porous materials means it often leaves behind mold roots, or hyphae, which can regrow over time. This limitation makes bleach a temporary solution rather than a long-term fix for mold infestations in these materials.
To use bleach effectively on porous surfaces, dilute it with water at a ratio of 1 cup of bleach per gallon of water. Apply the solution directly to the moldy area using a spray bottle or sponge, ensuring thorough coverage. Let it sit for 10–15 minutes to allow the bleach to kill surface mold. Scrub the area with a stiff brush to remove visible mold, then rinse with clean water and dry completely. Despite these steps, be aware that mold may return if the underlying issue—moisture—is not addressed.
A persuasive argument against relying solely on bleach for porous surfaces is its potential to exacerbate the problem. Bleach contains water, which can further saturate porous materials, creating a more favorable environment for mold growth. Additionally, bleach’s harsh chemicals can weaken materials like wood or grout over time. For these reasons, alternatives like vinegar, hydrogen peroxide, or commercial mold removers designed for porous surfaces are often recommended. These options penetrate more effectively and are less likely to cause damage.
Comparing bleach to other mold treatments highlights its shortcomings on porous surfaces. For instance, hydrogen peroxide (3% solution) not only kills mold but also breaks down into water and oxygen, leaving no harmful residue. Similarly, vinegar’s acidic nature penetrates porous materials better than bleach, disrupting mold’s cellular structure. While bleach is effective for non-porous surfaces like tiles or glass, its use on porous materials should be reconsidered in favor of more suitable solutions.
In conclusion, while bleach can kill surface mold on porous materials, it falls short as a comprehensive solution due to its inability to penetrate deeply and its potential to worsen moisture issues. For porous surfaces, prioritize addressing the root cause of mold—excess moisture—and consider using alternative treatments like hydrogen peroxide or vinegar. If mold infestation is severe, consult a professional to ensure complete removal and prevent long-term damage to your home.
Understanding Spore-Forming Bacteria: Survival Mechanisms and Health Implications
You may want to see also

Long-term prevention using bleach
Bleach can indeed kill mold spores on non-porous surfaces, but its effectiveness diminishes when mold infiltrates porous materials like drywall or wood. Long-term prevention using bleach requires a strategic approach, focusing on surface treatment and environmental control rather than relying solely on its biocidal properties. For instance, a 1:10 bleach-to-water solution (1 cup bleach per gallon of water) is commonly recommended for cleaning mold-prone areas like bathrooms. However, this method is most effective as a maintenance tool in conjunction with other preventive measures, not as a standalone solution.
Analyzing bleach’s limitations reveals why it falls short for long-term prevention. While it kills surface mold, it doesn’t penetrate porous materials, leaving embedded spores intact. Additionally, bleach’s harsh chemicals can degrade surfaces over time, and its residue may contribute to discoloration or damage. For example, repeated bleach use on grout or painted walls can weaken these materials, creating conditions conducive to future mold growth. Thus, bleach is best used as a temporary fix rather than a cornerstone of prevention.
To maximize bleach’s role in long-term prevention, integrate it into a broader strategy. Start by addressing moisture sources—fix leaks, improve ventilation, and maintain humidity below 50%. After cleaning mold with bleach, follow up with a borate-based solution, which penetrates porous materials and inhibits future growth. For instance, applying a borate wood preservative to treated areas can provide lasting protection. This two-pronged approach leverages bleach’s immediate effectiveness while addressing the root causes of mold.
A persuasive argument for bleach’s limited role in long-term prevention lies in its environmental and health impacts. Bleach releases volatile organic compounds (VOCs) when used, which can irritate respiratory systems and exacerbate allergies. Alternatives like vinegar or hydrogen peroxide are gentler and equally effective on non-porous surfaces. For households with children, pets, or individuals with sensitivities, these alternatives offer a safer, more sustainable option. Prioritizing non-toxic solutions aligns with long-term health and environmental goals.
In conclusion, while bleach can kill mold spores on surfaces, its role in long-term prevention is supplementary. Effective strategies combine targeted bleach use with moisture control, material treatment, and safer alternatives. For example, using bleach to clean bathroom tiles monthly while installing a dehumidifier and sealing porous surfaces creates a robust defense against mold. By understanding bleach’s strengths and limitations, homeowners can craft a preventive plan that ensures lasting results without unintended consequences.
Mastering Mushroom Identification: A Step-by-Step Guide to Making Spore Prints
You may want to see also
Explore related products
$13.48 $14.13

Bleach concentration for mold removal
Bleach can indeed kill mold on non-porous surfaces, but its effectiveness hinges on concentration. Household bleach, typically 5-8% sodium hypochlorite, is often diluted for mold removal. The recommended ratio is 1 cup of bleach per 1 gallon of water, creating a solution that’s roughly 0.5% sodium hypochlorite. This concentration is strong enough to kill surface mold but mild enough to minimize damage to materials like tile or glass. Stronger solutions, while more potent, risk discoloration and material degradation, making dilution a critical step in the process.
However, concentration alone doesn’t guarantee success. Bleach’s active ingredient, sodium hypochlorite, works by breaking down mold cells but struggles to penetrate porous surfaces like wood or drywall. In these cases, even a properly concentrated bleach solution may only kill surface mold, leaving spores embedded deeper within the material intact. This limitation underscores the importance of assessing the surface type before application. For porous materials, alternative methods like vinegar or professional remediation may be more effective.
Applying bleach at the correct concentration requires precision and caution. After mixing the solution, use a spray bottle or cloth to apply it directly to the moldy area, ensuring full coverage. Let the solution sit for 10-15 minutes to allow it to work, then scrub the area with a brush to remove residual mold. Rinse thoroughly with water and dry the surface completely to prevent moisture buildup, which can encourage new mold growth. Always wear protective gear, including gloves and a mask, to avoid skin and respiratory irritation.
Comparing bleach to other mold removal agents highlights its strengths and weaknesses. While bleach is affordable and readily available, its effectiveness is surface-dependent. Vinegar, for instance, is safer for porous materials but less potent against stubborn mold. Commercial mold removers often contain stronger chemicals but come at a higher cost. Bleach’s optimal concentration strikes a balance between efficacy and safety, making it a practical choice for non-porous surfaces when used correctly. Understanding its limitations ensures it’s applied where it’s most effective.
In practice, maintaining the correct bleach concentration is key to successful mold removal. Over-dilution reduces its killing power, while over-concentration risks damage. For large mold infestations, consider consulting a professional, as DIY solutions may not suffice. Regularly inspect areas prone to moisture, such as bathrooms and basements, and address mold promptly to prevent spread. While bleach isn’t a universal solution, when used at the right concentration and on appropriate surfaces, it remains a reliable tool in the fight against mold.
Mastering Spore Syringe Creation: A Step-by-Step DIY Guide
You may want to see also

Alternatives to bleach for mold spores
Bleach, while commonly used, is not always the most effective or safest solution for killing mold spores. Its effectiveness is limited to non-porous surfaces, and it can even exacerbate mold growth by providing moisture to porous materials. Fortunately, several alternatives offer robust mold-killing properties without the drawbacks of bleach.
Vinegar: A Natural Powerhouse
White distilled vinegar, with its 5–8% acetic acid concentration, is a proven mold killer. Its acidic nature breaks down mold structure and prevents future growth. To use, apply undiluted vinegar directly to the affected area, let it sit for one hour, then scrub and wipe dry. This method is safe for most surfaces, including wood and tile, but test on a small area first to avoid discoloration. Unlike bleach, vinegar is non-toxic, making it ideal for households with children or pets.
Hydrogen Peroxide: Oxygen-Powered Cleaning
A 3% hydrogen peroxide solution is both antifungal and antibacterial, effectively killing mold spores on contact. Pour it into a spray bottle, apply to the moldy surface, let it bubble for 10 minutes, then scrub and wipe clean. This method is particularly effective on bathroom surfaces like grout and shower walls. Hydrogen peroxide decomposes into water and oxygen, leaving no harmful residue, and is a safer alternative for those sensitive to harsh chemicals.
Baking Soda: Gentle Yet Effective
Baking soda is a mild, non-toxic option that inhibits mold growth by creating an alkaline environment. Mix one teaspoon of baking soda with two cups of water to create a paste, apply it to the moldy area, let it dry, then scrub off. For added power, combine baking soda with vinegar or hydrogen peroxide. This method is gentle on surfaces and safe for use around food preparation areas, making it a versatile choice for kitchens and bathrooms alike.
Essential Oils: Nature’s Antimicrobials
Certain essential oils, such as tea tree, eucalyptus, and thyme, possess potent antifungal properties. Mix 10–15 drops of tea tree oil with one cup of water, spray onto the moldy surface, and let it dry without rinsing. While not as fast-acting as vinegar or peroxide, essential oils provide long-lasting protection against mold recurrence. However, they are more expensive and should be used sparingly. Always dilute essential oils properly, as their concentrated forms can irritate skin and eyes.
Commercial Mold Removers: Convenience with Caution
For severe infestations, commercial mold removers like Concrobium or Mold Armor offer convenience and strength. These products typically contain non-toxic, eco-friendly ingredients that encapsulate and eliminate mold spores. Follow the manufacturer’s instructions carefully, as application methods vary. While effective, these products can be costly and may contain chemicals that require ventilation during use. Always wear gloves and a mask when handling commercial solutions.
In summary, alternatives to bleach provide safer, often more effective solutions for killing mold spores. Whether opting for natural remedies like vinegar and essential oils or commercial products, the key is to choose a method suited to the surface and severity of the mold. Each alternative offers unique benefits, ensuring there’s a viable option for every situation.
Mastering Spore: A Beginner's Guide to Evolving Your Creature
You may want to see also
Frequently asked questions
Bleach can kill surface mold but is not effective at killing mold spores, especially on porous materials.
Bleach is primarily a surface disinfectant and cannot penetrate porous surfaces like wood or drywall, where mold spores can remain dormant.
Use mold-specific products containing ingredients like hydrogen peroxide, vinegar, or commercial fungicides designed to penetrate surfaces and kill spores.
Yes, bleach can worsen mold issues by providing moisture to mold spores and not addressing the root cause, especially in porous materials.
Bleach is safe on non-porous surfaces like tiles and glass but should be avoided on porous materials, fabrics, or metals, as it can cause damage.































